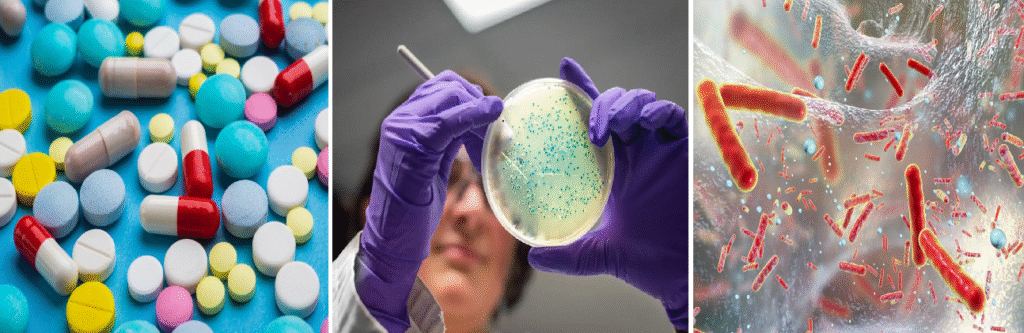
Antibiotic resistance deaths forecast 2050

Antibiotic resistance is emerging as one of the most serious global health threats, with experts warning that millions of lives are at stake. Current projections indicate that deaths from drug-resistant bacterial infections will rise sharply, climbing from 1.27 million in 2019 to 1.91 million annually by 2050. Over the coming decades, this crisis could result in a staggering 39 million deaths worldwide.
However, experts stress that the outlook is not entirely bleak. More than one-third of these projected fatalities could be prevented through urgent measures, including the development of new antibiotics, improved access to quality healthcare, and stricter controls on antibiotic use in both medicine and agriculture. Without immediate intervention, the world faces a future where once-treatable infections once again become life-threatening on a massive scale.
Antibiotic resistance occurs when microbes evolve the ability to withstand drugs that once killed them. The misuse and overuse of antibiotics in both healthcare and farming have accelerated this process, allowing resistant strains to spread across borders. Despite the urgency, the exact scale of the problem has remained uncertain until now.
To address this gap, researchers from the Institute of Health Metrics and Evaluation (IHME) analyzed over 500 million medical records covering multiple regions and decades. Their findings show that deaths attributable to antibiotic resistance rose from 1.06 million in 1990 to 1.27 million in 2019. Interestingly, the number then dropped slightly to 1.14 million in 2021, a decline largely linked to covid-19 restrictions which temporarily reduced the spread of other infections.
The research also highlights contrasting age trends. While deaths among children under five decreased by more than 50 percent due to better healthcare and vaccinations, fatalities among adults over 70 surged by over 80 percent. This suggests that elderly populations are becoming increasingly vulnerable to resistant infections.
Forecasts for the coming decades paint a concerning picture. In the most likely scenario, global deaths rise to 1.91 million annually by 2050. Yet, two alternative scenarios demonstrate the potential for hope. If new antibiotics are developed to combat the most dangerous bacteria, around 11 million deaths could be prevented. Furthermore, expanding access to quality healthcare worldwide could save even more lives.
While this study is considered more comprehensive than earlier forecasts, some experts caution against overconfidence in long-term predictions. Drug-resistant microbes can emerge or vanish unexpectedly, and black swan events can drastically alter trends. Moreover, the risk of death from antibiotic resistance varies between countries. In areas with weaker healthcare systems, resistant and non-resistant infections may prove equally fatal due to limited treatment options.
Despite these uncertainties, one message is clear: without decisive global action, antibiotic resistance could become one of the deadliest challenges of the 21st century. Strengthening healthcare systems, developing new drugs, and improving responsible antibiotic use are vital to prevent millions of unnecessary deaths.